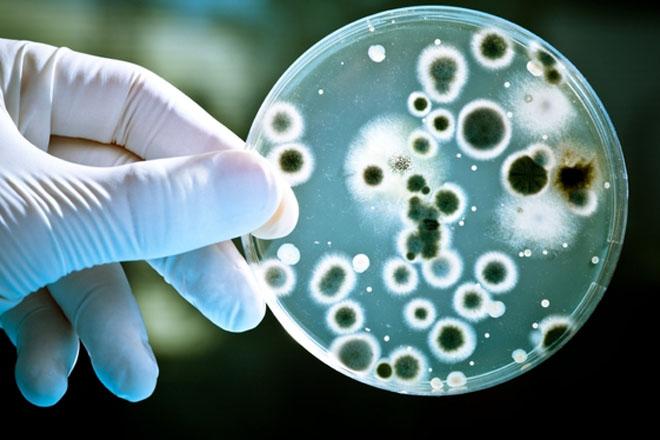
post image

У нас как всегда за неделю до нового месяца происходят либо новые умелки, либо изменения в поведении)))
Заметила такую закономерность! ☝
Во-первых, Регина больше не хочет пить из бутылочки молочко перед сном, лежа у меня на руках. 😭Отталкивает, вырывается! Надо теперь пить сидя, потом ложить в кроватку и спать!
Это было наше время...❤Как-то грустно...😢 Когда теперь смогу ее обнимать так долго?... Обычно, после тяжелого дня, обе уже уставшие, после того как доча пососет грудь, брала ее на ручки, давала бутылочку со смесью (докармливаю с 4 мес на ночь) и она засыпала у меня на руках, потом перекладывала ее в кроватку!
Во-вторых, больше не надо качать!!! Этому я конечно рада! Хотя и качала не на руках, а в кроватке с маятником.
Стала замечать, что когда качаю, она вертится, крутится, головой мотает из стороны в сторону. Попробовала раз не качать, а положила ее, дала соску, накрыла одеялком и положила на нее руку, пела песенку. Сразу уснула без ворочаний!)))
Теперь так и спим))
Меня поражает как быстро ребенок взрослеет! Как четко она сама для себя определяет, как теперь ей будет удобно!
И конечно, хвалю себя за то, что чувствую ее потребности😊
И еще раз убеждаюсь в том, что всему свое время ☝(это касается и сна на руках, пеленок, сосок, бутылочек, качаний и т.д.)
#loja_mood
Комментарии
@elena27101988 обязательно будет! Вот касаемо рук, у меня тоже запись была! До 3,5 месяцев она спала ТОЛЬКО у меня на руках, при перекладывании на любую другую поверхность, просыпалась моментально!!! Пока в один прекрасный день не закатила истерику у меня на руках, да такую, что я скорую хотела вызывать- не могла понять в чем дело!!! Положила ее в кровать, она начала затихать, я стала качать в кроватке и она уснула!😱 Сказать, что для меня это был шок- ничего не сказать😁 с тех пор так и спим))) в своей кроватке!
@vera67, да пробую конечно,но засыпает только на ручках.Привыкла с Рождения с мужем Ее на ручках укачивали так как с коликами мучалась(теперь не знаю как отучить🤷🏽♀️
@elena27101988 до трех месяцев если не могут уснуть надо им помогать. Попробуйте поглаживание бровок или спинки,вдруг поможет
Когда же моя будет без укачивания на ручках спать...и вообще в кроватке ..только рядом с мамой спит
Растёт девочка )) а мы только рядом со мной хорошо спим (( хотя редко спали вместе
Это точно,все свое время и все временно. Мой тоже засыпил от груди или бутылки,а теперь надо в кроватке засыпать,и покачать,видимо из за болезни.
Сейчас будет пост, который мне сказал написать муж😂
Спасибо всем за вчерашнее мнение😅 благодаря @elle_s я узнала, что таки у неё они тоже круглые🤦🏻♀️ и тоже разворачиваются, но реально по-другому пробита дырка в ухе, и у меня они тяжелее так как у неё только окантовка и вставлена пластина а у меня цельное золото, покрашенное, и ювелир с мужем долго обсуждали этот момент и думали как лучше сделать
Корооооооче
Сказал муж : иди теперь в прегги спрашивай как извиняться и получить комплект обратно🙄🤦🏻♀️
Итак!!! 🙏🏻😔
Очередная важная заметочка по болезням!!!
Как писала раньше 2 дня у меня была температура 38-39, БЕЗ насморка, БЕЗ горла... потом появились волдыри в горле как при ангине, а на третий день температура спала и вуаля! Появились волдыри на руках и ногах и тадаааам всем уже нашумевший вирус КОКСАКИ!!!
И сегодня заболела мелкая... тот же сценарий... пока темпер 38,5. Скорая была, назначили симптоматийное лечение.
Очень много шума в интернете про этот вирус. Хочу всех успокоить и убрать...
За все время беременности ещё такого не было 🙀 всю ночь я вертелась и просыпалась от любого шороха, а потом снова еле как засыпала... живот мой болел безумно, на левый бок ляжешь больно, на правый больно, на спину вообще ад 😭 так и не догадаешься, от чего это 🤷🏻♀️ толи желудок, толи что 🤷🏻♀️
•
Кстати, а вы верите в эту примету, что если во время беременности вытекает много молозиво, то это к скорым родам? 😂😄
У меня его так много стало, особенно когда я поем) Вчера в нете прочитала, об этом суеверие, л...

@loja, класс!👍🏽Я представляю какой у Вас шок был!!!!)))🙈Хорошо бы и нам так!🙏🏾я бы не против "висения на маме" если бы не домашние дела!😉